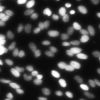
Image
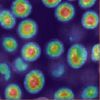
Probability Map

This network model is designed for star-convex object detection in 2D images. For more details, you can refer to the StarDist Networks by Uwe Schmidt, et al..
| Input Image | Analysis Code | Abbreviation | Description | Video |
|---|---|---|---|---|
|
fluo_nuclei | SEM Pore | This model is optimized for the automatic identification and analysis of pore structures in SEM images. It is recommended for image data with resolutions between 3–5 µm and pore diameters of approximately 150 µm, suitable for surface porosity inspection of common metals, porous ceramics, or polymer materials. | |
 |
sem_pore | Fluo Nuclei | This model possesses high versatility and can be applied to analyze cell nucleus images obtained from various fluorescence microscopy platforms (such as confocal, widefield, or multiphoton microscopes) for highly accurate nucleus region identification and quantitative analysis. | |
 |
mct_cfrp | MicroCT CFRP | This model is suitable for micro-computed tomography (micro-CT) images of carbon fiber reinforced plastics (CFRP). It is applicable to samples with image resolutions between 2 to 4 micrometers and fiber diameters of approximately 50 micrometers for structural identification and analysis. | |
 |
sem_steel_mb | SEM Steel MB | This model is suitable for microstructure images of martensite and bainite steels. The image source is an electron microscope, and the resolution is sufficient to clearly present the microstructure characteristics. It is suitable for distinguishing the boundary contours of different phase groups such as martensite and bainite, and performing structural identification and quantitative analysis. Since martensite and bainite have significant differences in morphology, distribution and mechanical properties, accurate segmentation helps to explore the correlation between heat treatment effects, strength sources and material properties. | |
 |
cryoem_lipsome | CryoEm Lipsome | This model is optimized for automatic identification and morphological analysis of liposome structures in Cryo-EM images. It is recommended for image data with a resolution of about 2 nm that can clearly show the outline of the lipid bilayer. It is suitable for quantitative analysis of liposome appearance, size and distribution in the fields of drug carrier design, nanoparticle research and biomedical material development. |

Click the top-left to open the main menu.